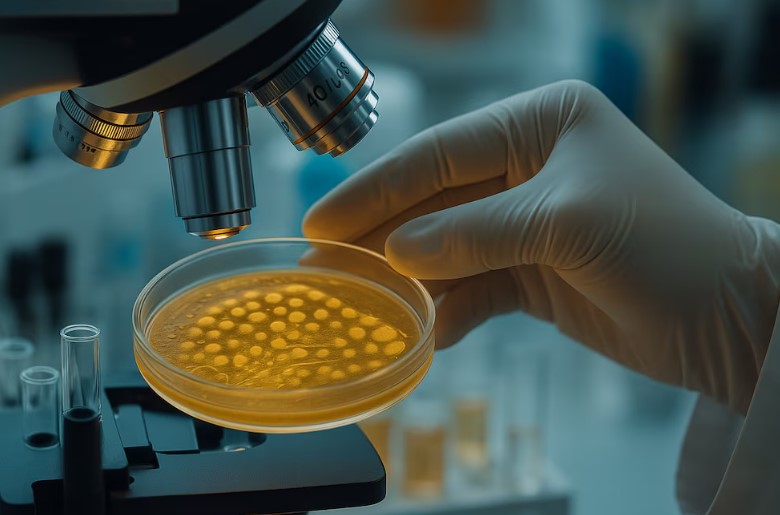

El Día de la Secretaria se celebra cada 4 de septiembre, pero la historia sobre cómo surgió no está muy clara. Su origen se encuentra envuelto de misterio y nunca se comprobó, pero no por eso deja de ser curiosa.
Existen dos historias sobre el origen del Día de la Secretaria. Una de ellas, sin comprobar, cuenta que durante la segunda etapa de la Revolución Industrial, en el siglo XIX, Christopher Sholes inventó la máquina de escribir. Su hija Lilian Sholes fue una de las primeras personas en comprobar la eficacia del invento. De esta manera, se convirtió en la primera mujer que se presentó en público escribiendo a máquina.
En Estados Unidos, en homenaje al centenario de su nacimiento, el 30 de septiembre de 1850, los fabricantes de máquinas de escribir realizaron en 1950 diversas actividades para conmemorar la fecha. Entre ellas, un concurso para elegir la mejor dactilógrafa, que se repitió año a año el 30 de septiembre con la participación de muchas secretarias. Los exitosos festejos llevaron a que la asociación que nuclea a las secretarias en ese país fijara un «Día de la Secretaria». Luego, en el mundo las organizaciones que reúnen a las secretarias en cada país fijaron una fecha diferente para cada festejo.
Otra historia, con mayor credibilidad, afirma que el festejo anual fue organizado por la Asociación Nacional de Secretarias (ahora conocida como la Asociación Internacional de Profesionales Administrativos), en 1952 en Estados Unidos. El festejo se llamó la «Semana Nacional de las Secretarias», y fue creado en conjunto con el ejecutivo de relaciones públicas Harry Klemfuss y un consorcio de fabricantes de productos de oficina.